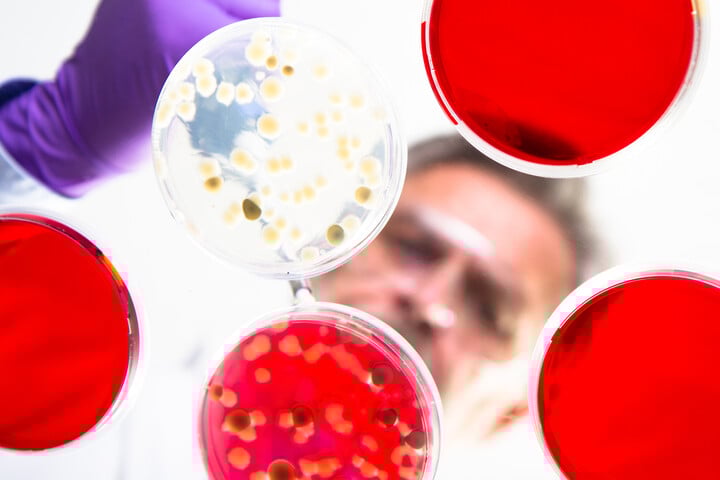
Az egerekkel érkező csendes fenyegetés

Egészség
Az egerekkel érkező csendes fenyegetés
A vírus, amely tüdőt vagy veséket támad, és sokáig rejtve marad
A hantavírus felfedezése
A hantavírusokat először a Koreai háború idején (1950-es évek) figyelték meg, amikor amerikai katonák súlyos vesebetegségben betegedtek meg.
A vírus nevét a Hantan folyóról kapta (Dél-Korea), ahol az első járványt tanulmányozták.
A kórokozót csak 1976-ban izolálták, Karl M. Johnson virológus vezetésével.
A vírus jellemzői
- A hantavírusok az Arenaviridae családba tartoznak (pontosabban: Bunyaviridae → Hantaviridae).
- Többféle típusuk van, melyek különböző klinikai képeket okoznak, attól függően, melyik régióban terjednek.
Két fő klinikai forma:
1. HFRS – Hemorrhagiás láz vese szindrómával
Jellemző főleg Európában és Ázsiában
Okozói: Hantaan, Dobrava, Seoul, Puumala vírusok
2. HPS – Hantavírus pulmonális szindróma
Főként Észak- és Dél-Amerikában
Okozói: Sin Nombre, Andes, Laguna Negra vírusok
Terjesztés
- Természetes hordozók: egerek, pockok, rágcsálók (vírust ürítenek a vizeletükben, székletükben, nyálukban)
- Emberi fertőzés:
- belélegzéssel (szennyezett por → aeroszol)
- ritkábban harapással
- Dél-Amerikában emberről emberre is terjedhet az Andes-vírus esetén
Lappangási idő
- Átlagosan 1–5 hét (széles skála: 7–60 nap)
Tünetek
Kezdeti tünetek (mindkét típusnál hasonló):
- Hirtelen magas láz
- Hidegrázás
- Fejfájás
- Izomfájdalmak (derék, lábak)
- Hányinger, hányás
- Hasi fájdalom
- Fáradtság
1. HFRS – Veseszövődményes forma (Európa, Ázsia)
5 szakasz:
|
Fázis |
Jellemzők |
|
1. Lappangás |
7–30 nap, tünetmentes |
|
2. Láz |
3–7 nap, influenzaszerű tünetek |
|
3. Hipotenzív |
Vérnyomásesés, sokkveszély |
|
4. Oliguriás |
Veseműködés csökkenése, ödéma, veseelégtelenség |
|
5. Diurézis |
Hirtelen vizeletmennyiség-növekedés, felépülés kezdete |
Halálozás: 0,1–10%
A Puumala-vírus enyhébb, Hantaan és Dobrava súlyosabb lefolyású
2. HPS – Tüdőszindrómás forma (Amerikák)
|
Időszak |
Tünetek |
|
1–5. nap |
Láz, izomfájdalom, gyengeség |
|
5–7. nap |
Légzési nehézség, köhögés, hipoxia, tüdőödéma |
|
7+ nap |
Gyors állapotromlás, légzési elégtelenség, halál vagy intenzív terápia szükséges |
Halálozás: akár 35–50%
Az Andes-vírus emberről emberre is terjedhet!
Halálozási arány (összefoglaló)
|
Típus |
Halálozás |
|
HFRS (Európa/Ázsia) |
0,1–10% |
|
HPS (Amerika) |
35–50% |
Kezelés
Nincs specifikus antivirális gyógyszer vagy jóváhagyott vakcina
- Ribavirin: HFRS esetén csökkentheti a halálozást, ha nagyon korán alkalmazzák
- Tüneti kezelés:
- Folyadékpótlás
- Szervtámogatás (dialízis, lélegeztetés)
- Légzéstámogatás HPS esetén
Megelőzés
- Rágcsálók elleni védekezés: irtás, élelem lezárása
- Poros, zárt terek (pl. fészerek, alagsorok) szellőztetése takarítás előtt
- Maszk viselése fertőzött területen végzett munka közben
- Védőfelszerelés egészségügyben (Andes-vírusnál emberről emberre terjedés lehetséges!)
Érdekességek
- Európában a Puumala-vírus okozta HFRS enyhébb lefolyású, de gyakran diagnosztizálatlan marad
- Magyarországon is előfordulhat, főleg vadászok, túrázók, erdőgazdálkodók körében
- A „Sin Nombre vírus” (USA, 1993) nevét azért kapta, mert a kutatók nem akarták stigmatizálni a területet
|
Tulajdonság |
Érték |
|
Kórokozó |
Hantavírus (különböző típusok) |
|
Terjedés |
Rágcsálók váladékai, aeroszol |
|
Lappangás |
7–60 nap |
|
Tünetek |
Láz, izomfájdalom → vese- vagy tüdőkárosodás |
|
Halálozás |
HFRS: 0,1–10%, HPS: 35–50% |
|
Kezelés |
Ribavirin (korai), tüneti ellátás |
|
Vakcina |
❌ Jelenleg nincs (fejlesztés alatt) |
